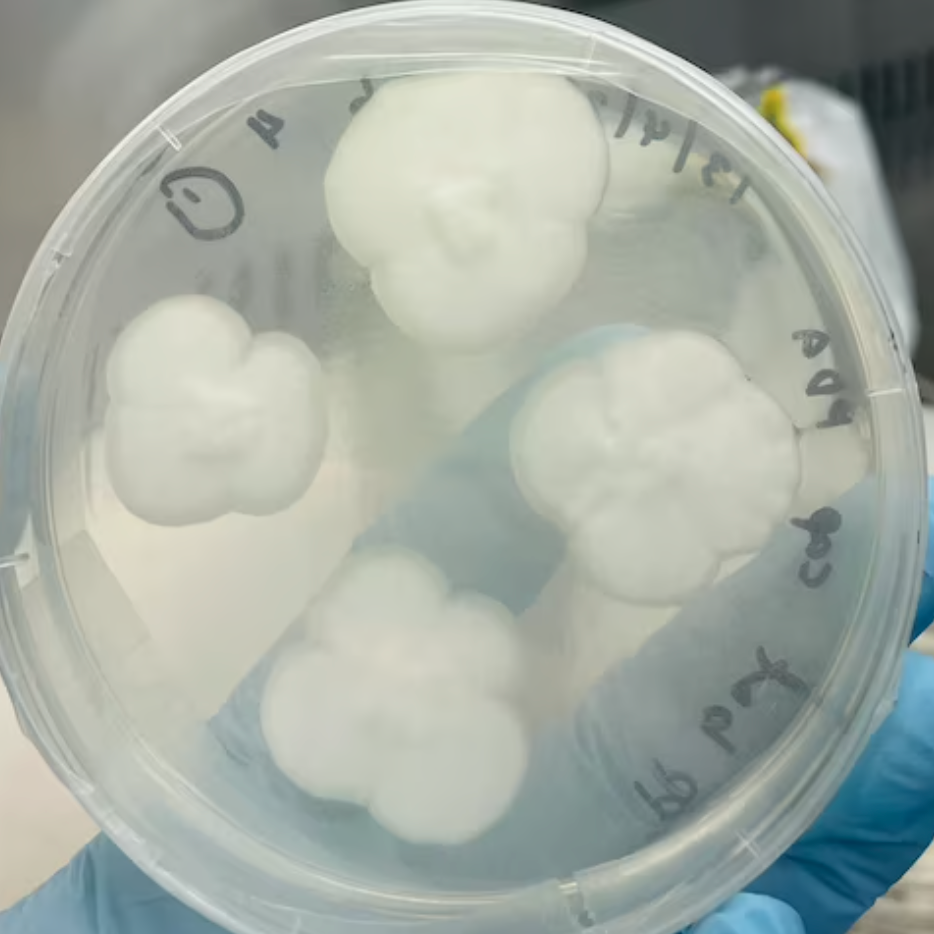

The Weekly Dive #30
New York City is sinking! More everyday items discovered to hold PFAS, among them: contact lenses and food . SFO becomes the first US airport to test wastewater to detect Covid-19. Seaweed-based straw gets more funding. A tiny drone that can stay indefinitely under water gets €2M. Swiss Ecorobotix receives $52M to enter the US market. The Biden-Harris administration releases $600M to modernize water power in the US. This week, we are highlighting Chris Clapp, one of HydroDAO’s key advisors. Learn about his impressive background and why he is passionate about water.
Your weekly Bonus – Oceans have been absorbing heat, but there’s a catch.
This week’s quote:
In a 100-year period, a water molecule spends 98 years in the ocean, 20 months as ice, about 2 weeks in lakes and rivers, and less than a week in the atmosphere
Get Featured on Our Newsletters!

This Could Be Your Spot For Your Product, Service, Or Event On Our Newsletters!
As The Weekly Dive provides global exposure to the water leaders of today, we are now accepting features from leading edge companies and people in the water industry. Please share your noteworthy news, innovations and events with our community at didier@hydrodao.io
What’s New with Water Innovations?

A new tiny drone is in the works that can stay underwater almost indefinitely
A Swiss and Norwegian joint venture has just received 2 million euros in funding to develop a reliable, permanent drone system, initially focusing on the aquaculture sector.

Seaweed-based straw maker Loliware scaling up with new financing
Loliware raised $6 million in a recent round of pre-series A funding, bringing its total to $15.4 million.

MWRD joins Water Research and Innovation workshop
The Megacity Alliance for Water and Climate organized a workshop on Water Research and Innovation (WRI).

SFO becomes first US airport to launch airplane wastewater testing for Covid-19
“CDC appreciates the collaboration with SFO to further enhance these efforts.”
What’s New in the Industry?

Brief: Switzerland’s Ecorobotix raises $52m to bring crop protection ‘bots to the Americas
Ecorobotix will use the funding to expand its business, with a special focus on bringing its ‘bots to the Americas.

Biden-Harris Release $600M To Modernize And Accelerate Water Power In The US
President Biden’s Investing to Increase Access to Reliable Clean Power for Americans.

Associations endorse bill to hold PFAS polluters liable for cleanup
“CERCLA is intended to hold polluters accountable for the damage they cause”

Senators Working To Address Liability Fears Over U.S. EPA’s PFAS Rules
“Top senators to address liability fears from farmers and water treatment agencies”
What’s New in the Science?

New York City, it turns out, is sinking under its own weight
Scientists have discovered that New York City appears to be sinking at a rate of a few millimeters yearly. But why?

US food pesticides contaminated with toxic ‘forever chemicals’
PFAS at ‘potentially dangerous’ levels in widely used chemicals sprayed on food crops.

Your Contact Lenses May Be a Hidden Source of ‘Forever Chemicals’
A lab has detected signs of PFAS ‘forever chemicals’ in 18 popular brands of contact lenses.

Researchers develop crystals from plants to purify pharmaceutical-polluted water
The porous crystals will degrade pharmaceutical molecules in the local municipal wastewater.
Chris is the Executive Director of the Ocean Sewage Alliance where he is on a journey to end wastewater pollution in coastal waters. Previously, Chris spent 18 years working for The Nature Conservancy as a marine scientist on Long Island.

Chris has made a tremendous impact on The Conservancy’s approach to water quality. His work in shellfish recovery led him to the realization that there was a larger problem to resolve: nutrient pollution from cesspools and septic systems. Consequently, he became TNC’s internal expert on wastewater technology – he drove policies and funding for nitrogen pollution mitigation and also facilitated the development and implementation of sustainable technologies. Given his unique ability to collaborate effortlessly with scientists, agency experts and local stakeholders, Chris has developed a wide and varied network of individuals. Chris is enthusiastic to share his knowledge and experiences to help scale successful programs, which he has already done beyond Long Island in locations including New England, Florida and Hawai’i. He is deeply invested in community engagement and continues to serve on the water quality advisory committees for the Towns of Southampton and East Hampton.
Thank you Chris for your leadership and passion for coastal waters and for your support to our HydroDAO community.
What’s in the Future?

Oceans have been absorbing the world’s extra heat. But there’s a huge payback
Record sea surface temperatures suggest the Earth is headed for ‘uncharted territory’ in terms of sea level rise, coastal flooding and extreme weather.